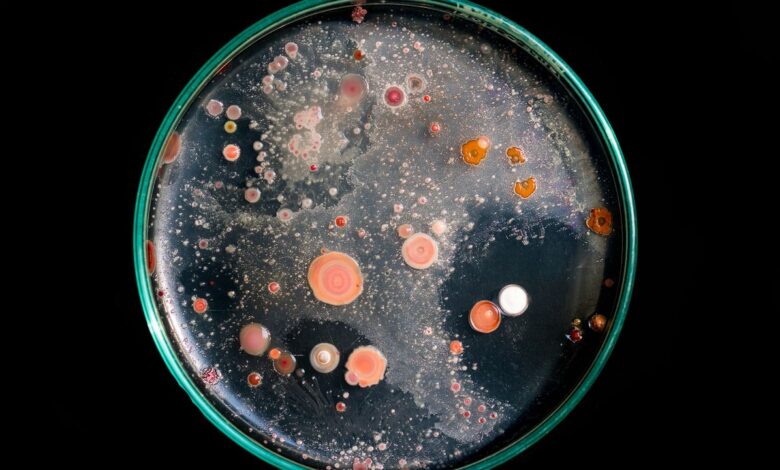

Reviven microbios que estuvieron congelados por milenios para saber si son peligrosos
El suelo congelado de las regiones polares, conocido como permafrost, encierra microbios prehistóricos como si fueran prisioneros. En esa gélida capa de agua y silicatos permanecen bacterias y virus que nunca tuvieron contacto con la civilización humana contemporánea. El aumento de la temperatura global amenaza con liberarlos al entorno. La ciencia se pregunta si, cuando eso ocurra, esos microorganismos volverán a activarse y cuál será su impacto real.
Un equipo de científicos de la Universidad de Colorado Boulder entró al PTRF (Permafrost Tunnel Research Facility), un túnel mohoso que funciona como centro de investigación militar sobre el permafrost. Allí recolectaron bacterias congeladas e intentaron devolverlas a la vida. Según su investigación publicada en Journal of Geophysical Research: Biogeoscience, lo consiguieron, aunque el crecimiento no respondió a sus expectativas.
“En el permafrost profundo y antiguo, el crecimiento microbiano es extremadamente lento, a menudo indetectable durante el primer mes tras el deshielo, lo que indica un período de retraso notable, en el que solo entre el 0.001 y el 0.01% de las células se renuevan por día”, explican los autores.
Aunque despertaron microbios encapsulados en el permafrost, las colonias crecieron a un ritmo casi indetectable. En condiciones óptimas de laboratorio, un grupo bacteriano común logra renovarse por completo en unas horas o días. En cambio, durante los primeros meses, los científicos observaron que los microorganismos liberados de esa prisión congelada reemplazaban apenas una de cada 100,000 células por día.
Después de seis meses de cultivo, las bacterias aceleraron su comportamiento. La universidad informó que algunas colonias incluso produjeron estructuras pegajosas llamadas “biopelículas”, visibles a simple vista.
El impacto de las bacterias atrapadas no es el que crees
La evidencia disponible indica que las bacterias que despiertan al descongelarse el permafrost no representan un riesgo directo para la salud humana. Los científicos no temen la aparición de una enfermedad nueva y mortal, sino el impacto profundo del microbio en el equilibrio climático del planeta.
Al “despertar”, las bacterias descomponen la materia orgánica atrapada durante miles de años y liberan grandes cantidades de dióxido de carbono y metano, dos de los gases de efecto invernadero más potentes. Este proceso alimenta un ciclo de retroalimentación que acelera el calentamiento global.
La reestructuración microbiana que reveló el estudio obliga a incluir un periodo de atraso en cualquier cálculo de impacto ambiental: los microbios pueden recongelarse antes de alterar el ecosistema o, si los veranos árticos se prolongan más de lo habitual, aumentar el riesgo de dañar el equilibrio climático.
«Puede que haya un solo día caluroso en el verano de Alaska, pero lo que importa mucho más es la prolongación de la temporada de verano hasta el punto en que estas temperaturas cálidas se extienden hasta el otoño y la primavera», dijo Tristan Caro, autor principal del estudio.
Además del riesgo climático, el deshielo del permafrost libera metales pesados y pesticidas, incrementa la probabilidad de incendios en pastizales, provoca el colapso de suelos que se desmoronan hacia el mar, altera ecosistemas árticos y obliga a comunidades a migrar.
DERECHOS DE AUTOR
Esta información pertenece a su autor original y fue recopilada del sitio https://es.wired.com/articulos/reviven-microbios-que-estuvieron-congelados-por-milenios-para-saber-si-son-peligrosos




